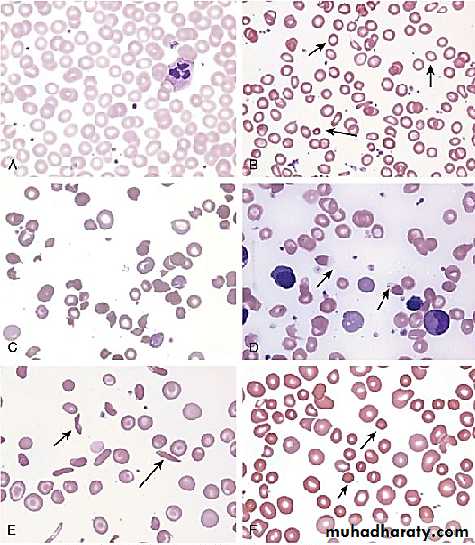

HEMATOLGY
Hemoglobin:Normal HB consists of 4globin chains and 4 heme groups. These globins chains are inhereted from parents..
At birth newborn has
Fetal HB (HbF) made of 2alpha and 2 gama chains form70% of total Hb
Adult type of HB (HbA) averages 30% (2alpha and 2beta).
HbA2 (a minor component of HbA) made of( 2alpha and 2 delta) chains form <1%.
Final Hb pattern: achieved between 6-12 mo of life
HbA ≥ 95%
HbA2 ≤ 3.5%
HbF< 2.5%
ANAEMIA
Defined as; reduction in Hb concentration or RBC volume (packed cell volume)below the accepted range for that age resulting in a lower ability for the blood to carry oxygen to the tissue.The anemia considered if;
Newborn (0-28 days) Hb <14g/dl
Infant1-12 monthes ;<10 g/dl
Children > 1 yr <11 g/dl.
It is important to consider the following developmental variations when evaluating an infant or child for anemia:
• Hemoglobin level and hematocrit are relatively high in the newborn; these values subsequently decline, reaching a nadir (7-9g/dl) at approximately 7 weeks of age for the premature infant and at 2 to 3 months of age for the term infant (10g/dl). (This condition is referred to as the “physiologic anemia” of infancy). Total hemoglobin concentration and hematocrit rise gradually during childhood .
• HbF level.
• Mean corpuscular volume (MCV) is relatively high during the neonatal period but declines during the latter part of infancy.
The MCV is lowest during infancy, gradually increasing with age during childhood, reaching adult levels during adolescence.
Normal Mean and Lower Limits of Normal for Hemoglobin, Hematocrit, and Mean Corpuscular Volume
CLASSIFICATION OF ANAEMIA
ACCORDING TO ETIOLOGY• Inadequate RBC production; as due to IDA or folic acid defeciency or vit. B12 deficiency or bone marrow depression as aplastic anemia.
• Loss of blood due to bleeding.
• Destruction of RBCs in the spleen and consumption as in chronic hemolytic anemia or intravascular destruction as in favism (G6PD deficiency).
ACCORDING TO BLOOD FILM
• Hypochromic Microcytic
• Normochromic normocytic
• Macrocytic
•
APPROACH TO DIAGNOSIS OF ANAEMIA
A
B
The initial laboratory evaluation of anemia involves a hemoglobin or hematocrit test to indicate the severity of the anemia. When the diagnosis of anemia has been substantiated, the workup should include a CBC with differential, platelet count, indices, and reticulocyte count.
Examination of the peripheral blood smear assesses the morphology of RBCs , white blood cells (WBCs), and platelets.
All cell lines should be scrutinized to determine whether anemia is the result of a process limited to the erythroid line or a process that affects other marrow elements.
C. LABORATORY STUDIES
Using data obtained from the indices and reticulocyte count, the workup can be organized on the basis of whether RBC production is adequate or inadequate and whether the cells are microcytic, normocytic, or macrocytic
If the reticulocyte production index (RPI):
• > 3 suggests increased production and implies either hemolysis or blood loss.
• < 2 suggests decreased or ineffective production for the degree of anemia. Reticulocytopenia signifies that:
the anemia is so acute in onset that the marrow has not had adequate time to respond.
reticulocytes are being destroyed in the marrow (antibody-mediated).
intrinsic bone marrow disease is present.
When conducting a workup for hemolysis, the best indicators of the severity of hemolysis are the hemoglobin level and the elevation of the reticulocyte count.
Biochemical evidence of hemolysis includes an increase in levels of bilirubin and lactate dehydrogenase and a decrease in haptoglobin.
• Normal
• Hypochromic microcytes (IDA)• Schistocytes (HUS)
• Blister cells (G6PD)
• Sickle cells (SCD)
• Spherocytes (autoimmune HA)
Morphologic abnormalities of RBC
Anemias of Inadequate Production
Anemias of Inadequate ProductionReduced red cell production may be due to:
1. Ineffective erythropoiesis - here red cell production occurs at a normal or increased rate but differentiation or survival of the red cells is defective (e.g. iron deficiency, folate deficiency ,chronic inflamation).
2. complete absence of red cell production (red cell aplasia ) e.g( Parvovirus 19 infection, aplastic anemia, leukemia).
Iron Deficiency Anemia
Etiology:The commonest cause of iron deficiency in children is:
• Inappropriate diet.• Blood loss.
• Malabsorption.
Inadequate intake of iron is common in infants because additional iron is required for the increase in blood volume accompanying growth and to build up the child's iron stores.
A 1-year-old infant requires an intake of iron of about 8 mg/day,
Iron may come from:
• Breast milk (low iron content but 50% of the iron is absorbed).• Infant formula (supplemented with adequate amounts of iron).
• Cow's milk (higher iron content than breast milk but only 10% is absorbed). Infants should not be fed unmodified cow's milk as its iron content poorly absorbed.
• Solids introduced at weaning, e.g. cereals (cereals are supplemented with iron but only 1% is absorbed).
Diagnosis of IDA
The diagnosis of IDA depend on:History (symptoms).
Examination (signs).
Investigations.
Therapeutic trial of iron.
Clinical Manifestations
In term infants, anemia caused solely by inadequate dietary iron usually occurs at9-24 mo of age and is relatively uncommon thereafter.
• Symptoms: Although mild iron deficiency is relatively asymptomatic, as it becomes more severe, the infant manifests:
• Signs: on physical examination, the infant is
Fatty.
Pale.
Other findings include tachycardia and a systolic murmur. If the anemia is very severe or if the patient has complications that put added stress on the cardiovascular system, there may be signs of congestive heart failure.
Other signs (such as koilonychia or angular cheilitis) are rare.
Stages of Iron Depletion
Iron deficiency causes serial changes in the blood before anemia develops.
Serum ferritin is reduced and eventually a microcytic, hypochromic anemia results.Usually the MCV (mean cell volume) and MCH (mean cell hemoglobin) fall before the hemoglobin, but the changes can occur together.
LABORATORY FINDINGS
• CBC & blood film:• IRON STUDY
Serum ferritin (an iron-storage protein)1st ↓• Early indicator of IDA:
↑Soluble transferrin receptor
↓Reticulocyte Hb concentration• In an otherwise healthy child, a therapeutic trial of iron is the best diagnostic study for iron deficiency as long as the child is re-examined and a response is documented.
DIFFERENTIAL DIAGNOSIS
• Anemia of chronic disease.• Thalassemia traits.
• Sideroblastic anemias.
• Lead poisoning
TREATMENT
IDA can be managed by administration of iron. This can be provided by the oral route at a dosage of 3-6 mg/kg/day of elemental iron. The maximum dose would be 150-200 mg of elemental iron daily.
Therapy is continued for a period of 2 to 3 months after the hemoglobin level has returned to normal; this allows replenishment of tissue iron stores.
Parenteral iron preparations are only used when malabsorption is present or when compliance is poor, because oral therapy is otherwise as fast, as effective, much less expensive and less toxic.
Blood transfusion is rarely necessary. It should only be used when heart failure is imminent or if the anemia is severe with evidence of substantial ongoing blood loss.
Dietary counseling must be simultaneously provided to caregivers to give the patient adequate amounts of dietary iron.
Absorption of iron is enhanced by vitamin C and proteins, but is inhibited by a number of constituents of food and drink, for example tannins (in tea ), phytates (in unrefined cereals), phosphates (in eggs), oxalates (in spinach) and polyphenols (in spinach, coffee).
Bottle-fed infants should receive an iron-containing formula until 12 months of age, and breastfed infants older than 6 months of age should receive an iron supplement. The introduction of iron-enriched solid foods at 6 months of age, followed by a transition to a limited amount of cow’s milk and increased solid foods at 1 year, can help prevent iron deficiency anemia. Teenage girls who are menstruating should have a diet enriched with iron-containing foods. A vitamin with iron may also be used.
Differential Diagnosis of MicrocyticAnemia That Fails to Respond to Oral Iron
Anemia of Chronic Disease
The anemia of chronic disease (ACD), also referred to as anemia of inflammation, is found in conditions where there is ongoing immune activation.It occurs in a wide a range of disorders including chronic inflammatory conditions, chronic infections, malignancies, autoimmunity, & graft-versus-host disease.
MECHANISM
• Decreased red cell life span, elevated levels of cytokines such as interleukin-1 may increase the macrophage’s ability to ingest and destroy erythrocytes.• Defective erythropoiesis, has been attributed to immune cell/cytokine-driven inhibition of erythropoietin production and suppression of the bone marrow.
• Accumulation of iron in reticuloendothelial macrophages despite low levels of serum iron. The diversion of iron from the circulation into the reticuloendothelial system results in functional iron deficiency, which results in the impaired heme synthesis and iron-restricted erythropoiesis that contribute to anemia.
CLINICAL MANIFESTATIONS
Although the important symptoms and signs associated with ACD are those of the underlying disease, the mild to moderate anemia can affect the patient’s quality of life.LABORATORY FINDINGS
CBC:Hemoglobin concentrations are generally 6-9 g/dL.
leukocytosis is common.
Absolute reticulocyte counts are normal or low.
Blood film: usually normochromic and normocytic, although some patients have modest hypochromia and microcytosis, particularly if there is concomitant iron deficiency.
Iron Study:
The serum iron ↓Total iron binding capacity: N or ↓
The serum ferritin level may be elevated.
This pattern of low serum iron and low-to-normal iron-binding protein (serum transferrin) is a regular and valuable diagnostic feature.
TREATMENT
The best approach to ACD is the treatment of the underlying disorder.Erythropoietic stimulating agents (ESAs), such as recombinant human erythropoietin (EPO) increase the hemoglobin level and improve activity and the sense of well-being. When using ESAs, treatment with iron is usually necessary to produce optimal effect.
• STUDY
IDA• α- OR β-THALASSEMIA MINOR
• ANEMIA OF CHRONIC DISEASE
• Hemoglobin• Decreased
• Decreased
• Decreased• RBC
• Decreased• Normal-increased
• Normal-decreased• MCV
• Decreased• Decreased
• Normal-decreasedMCH
• Decreased
• Decreased
NormalRDW
• Increased
• Normal
• Normal• Serum iron
Decreased• Normal
Decreased
• Serum ferritin• Decreased
• Normal
• Increased• Total Fe binding capacity
• Increased• Normal
• Decreased• Transferrin saturation
• Decreased• Normal
• Decreased• Transferrin receptor
• Increased
• Normal• Increased
• FEP• Increased
• Normal
• Increased
• Reticulocyte hemoglobin concentration
• Decreased
• Normal
• Normal-decreased
• Hemoglobin A2 or F
• Normal
• High β-thalassemia; normal
• α-thalassemia
• Normal